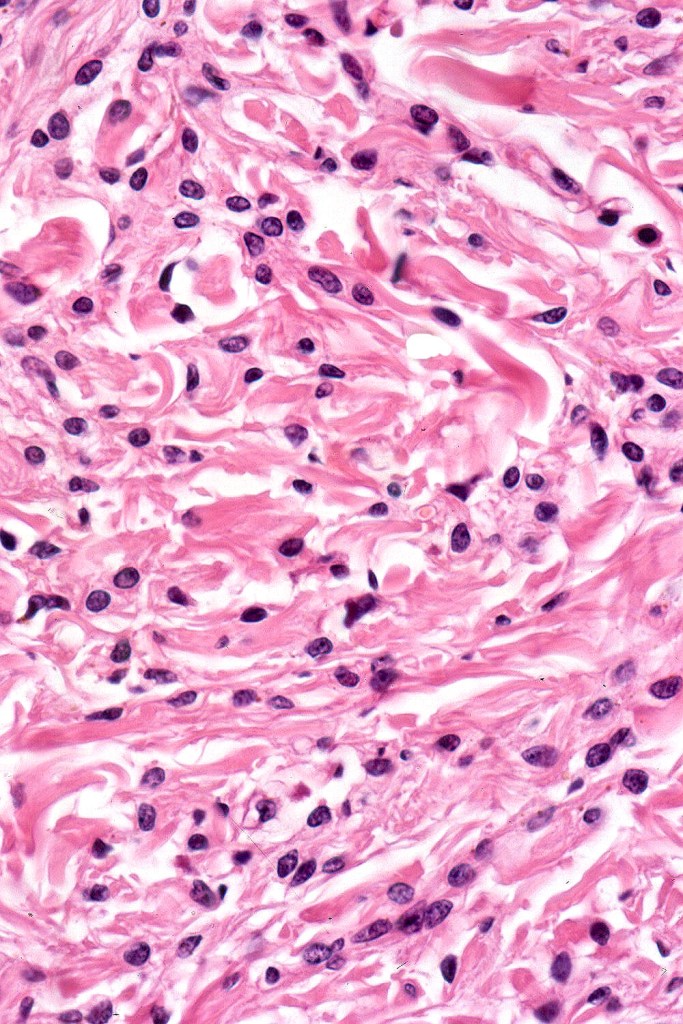
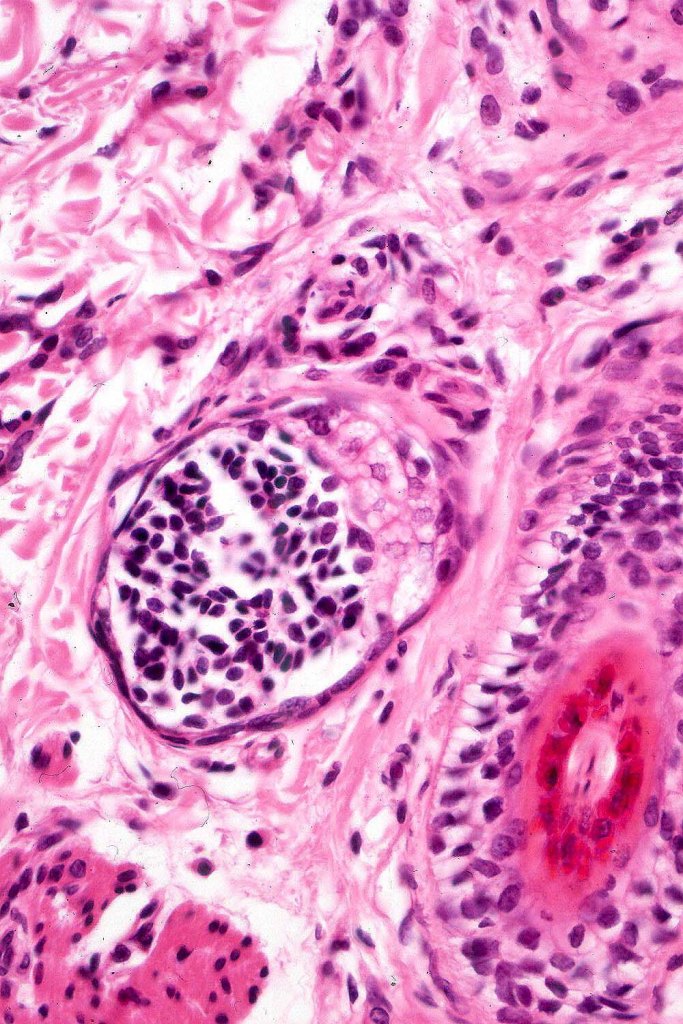
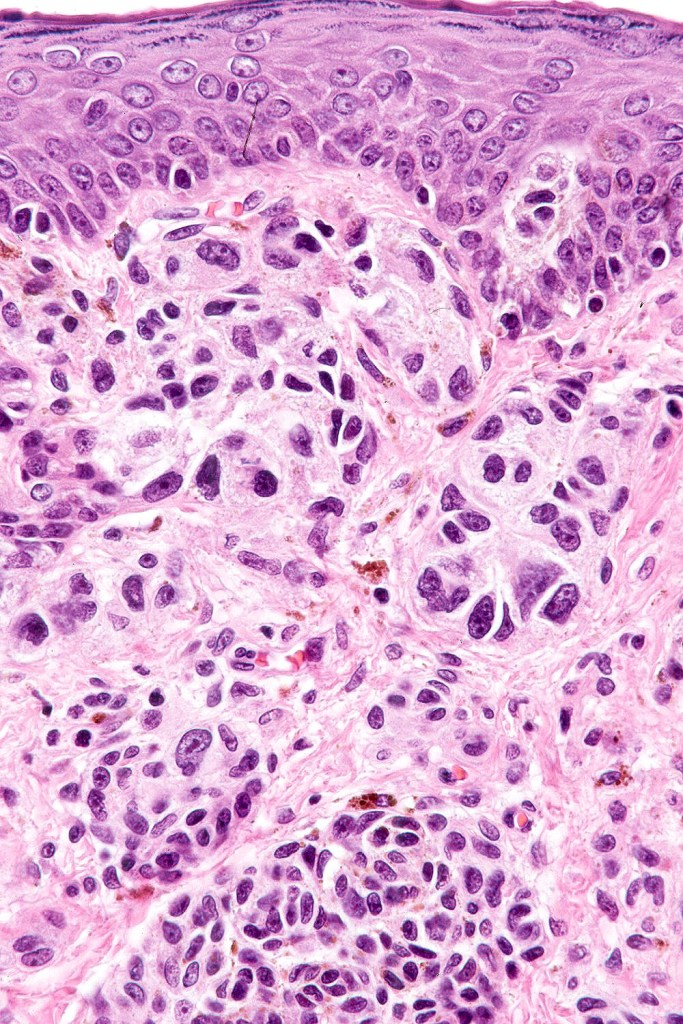
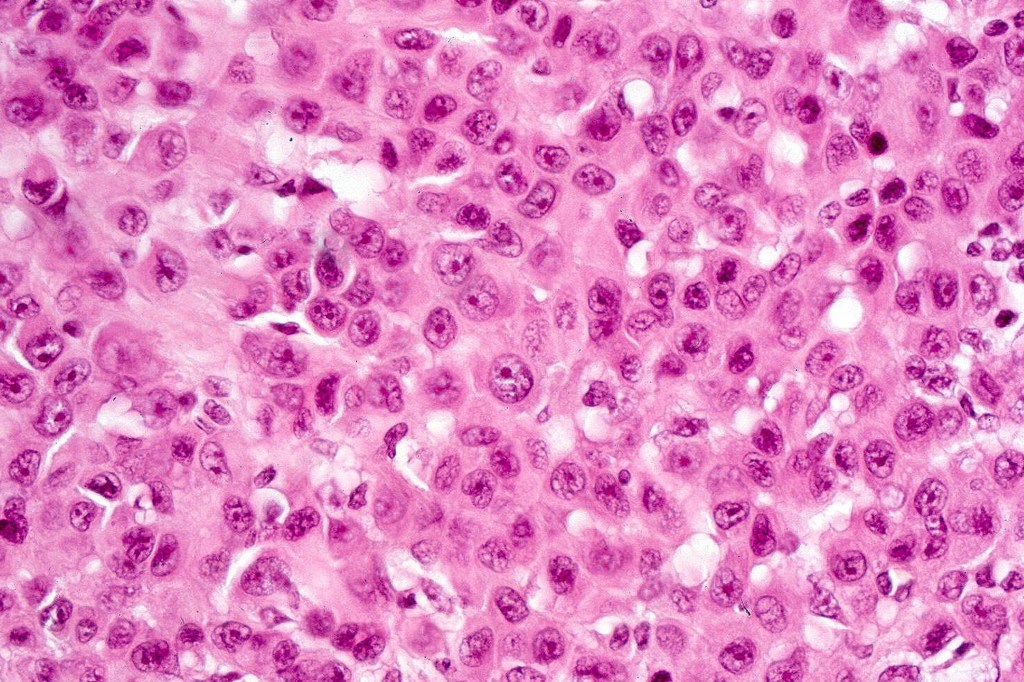
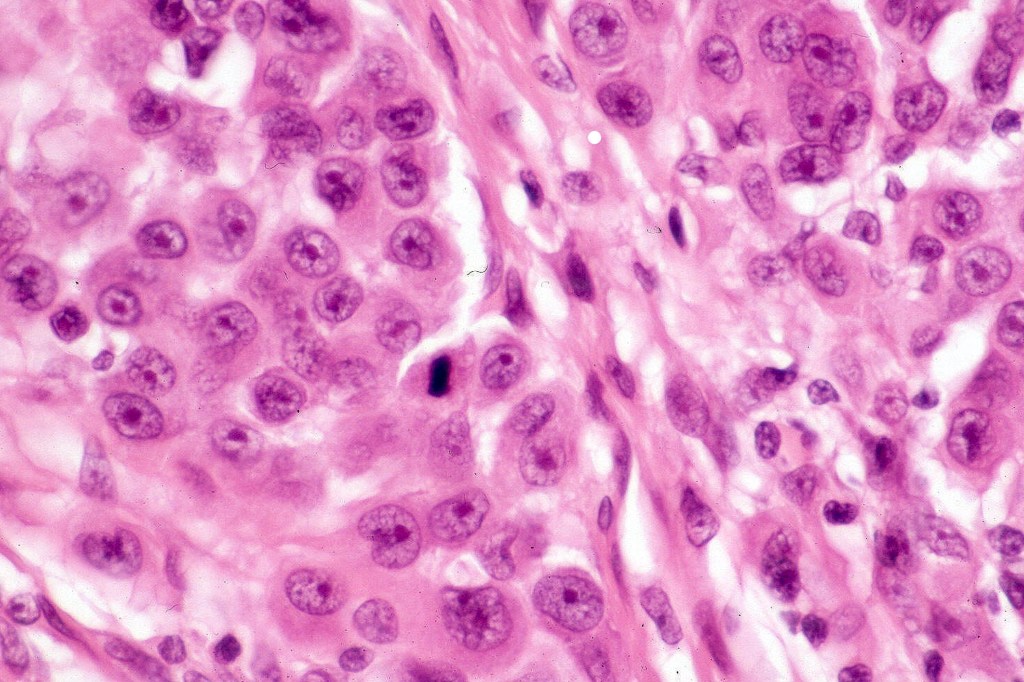
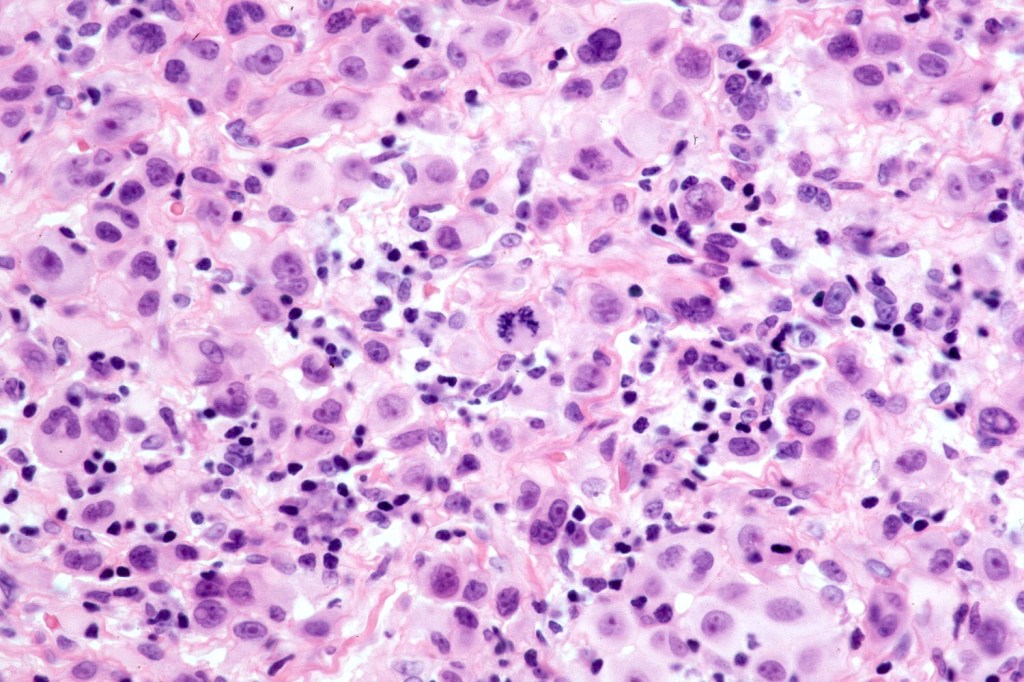
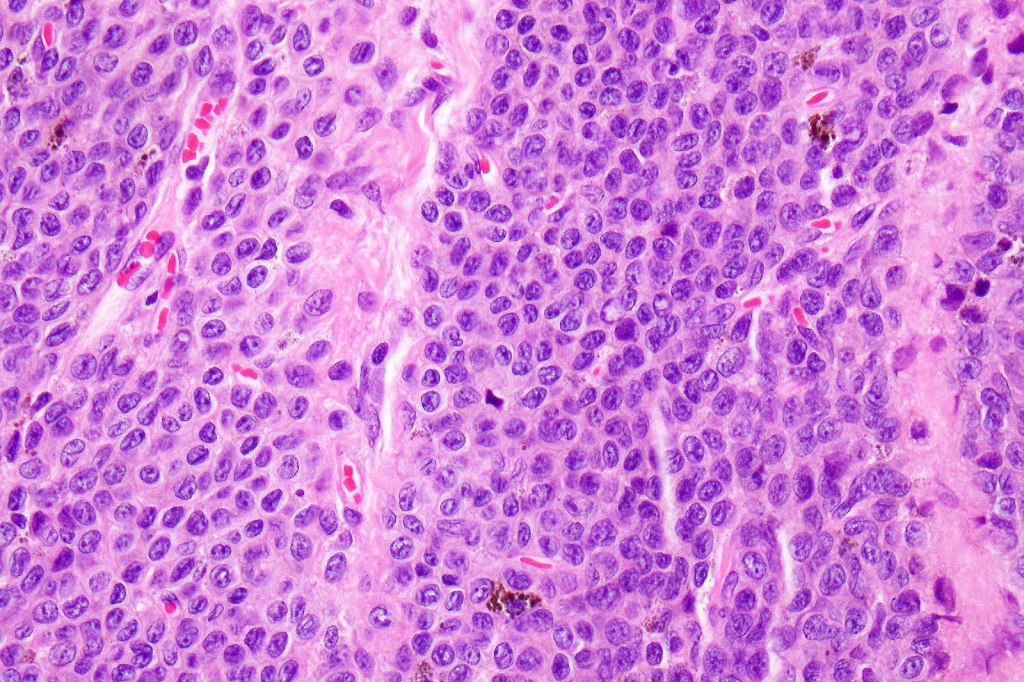
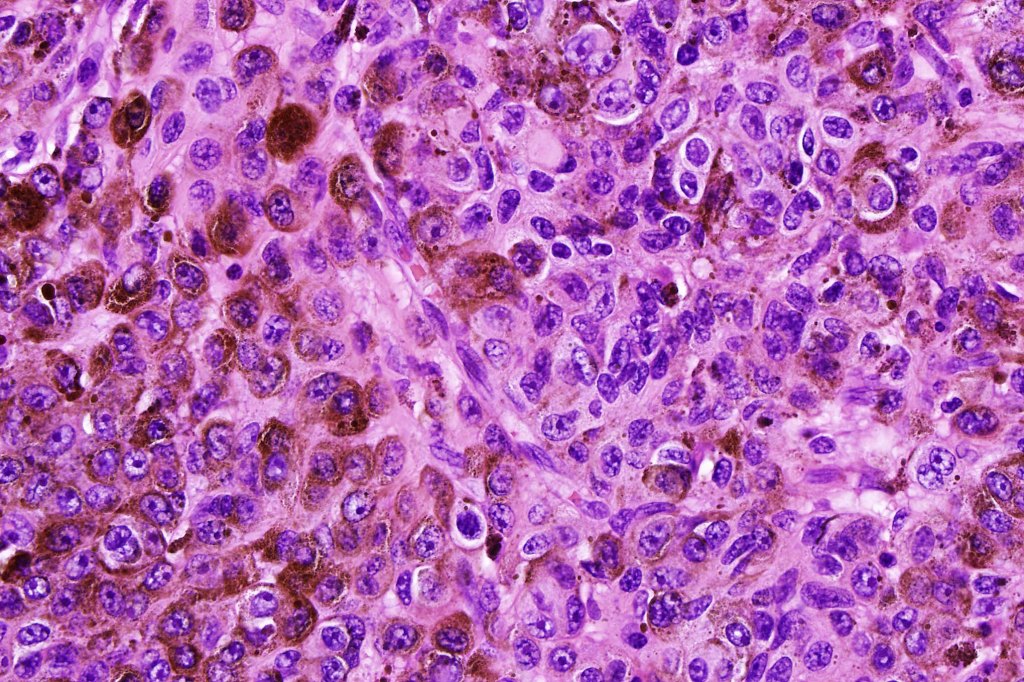
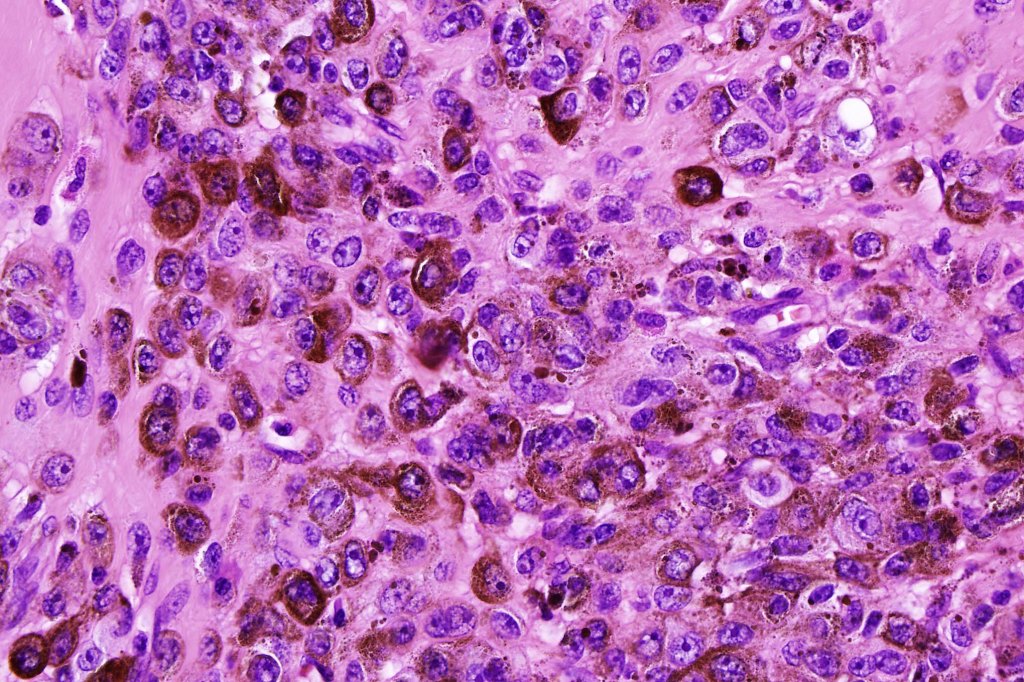
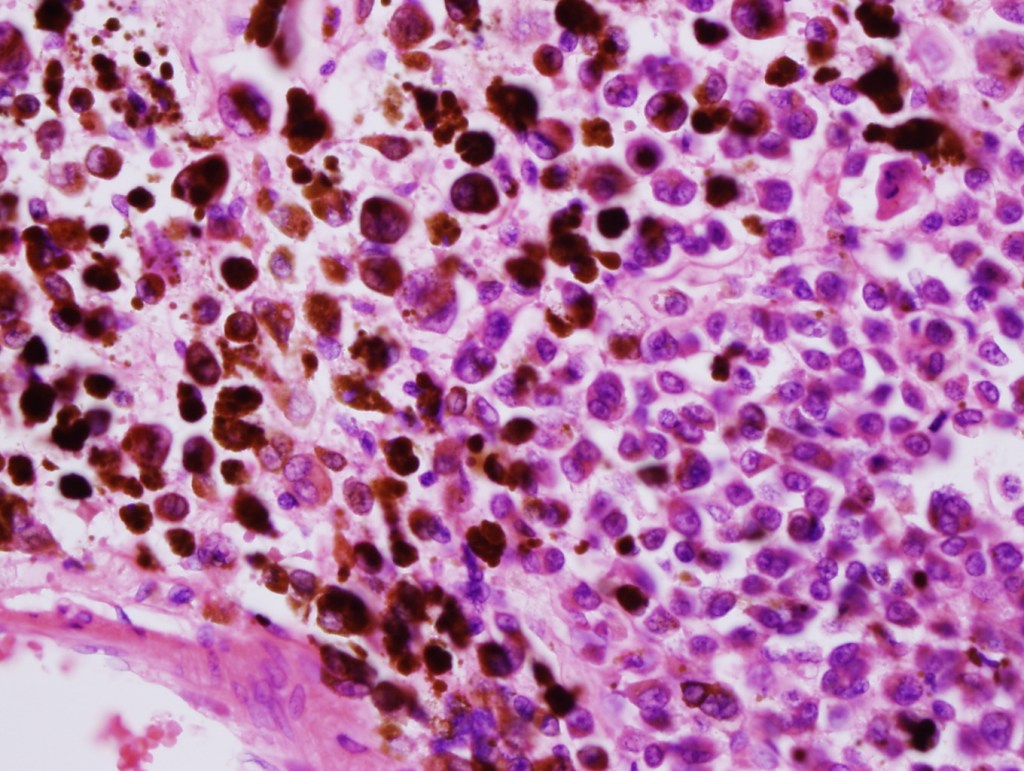

Clinical features
•Fairly common affecting 0.6-1.6% of the population
•Classified into small (1.5 cm or less in diameter, medium (1.5-20 cm) & large/giant/bathing trunk (>20 cm)
•Present at birth & sometimes multiple (satellite lesions)
.May be associated with hypertrichosis
•Trunk & legs>head & neck, feet & hands
. Development of a halo may be associated with spontaneous regression

Giant congenital nevi
•>20 cm in diameter
•M=F
•Head, neck & trunk
•Desmoplastic hairless hypopigmented variant
•Cerebriform variant
•Back lesions may be associated with leptomeningeal melanocytosis, spina bifida, intracranial melanoma & hydrocephalus (see below)
.Melanoma arising in large/giant congenital nevi- 3.8-18% in documented series)





Histological features
•May resemble banal melanocytic nevi & occasionally acquired nevi may resemble congenital nevi
•Most often are distinctive at scanning/low power examination due to the depth of involvement
•Hyperkeratosis, acanthosis and commonly papillomatosis
•Nested junctional component & nests within the papillary dermis
•Diffuse infiltrate of nevus cells often extending deeply into the dermis or beyond, single filing is often present at base & may involve the septa of the subcutaneous fat
•Involvement of appendages & arrector pili muscles
•Neurotization, neurofibroma-like lesions & neurocristic hamartoma
•Perineural sheath infiltration
•Blood vessel and lymphatic wall infiltration
•Superficial mitotic activity
.Proliferative nodules (described in a separate blog)
. Small congenital nevi have BRAF or NRAS mutations, medium & giant congenital nevi have NRAS>>BRAF mutations

Atypical congenital nevus of the neonate
•Very exceptional finding, generally in small congenital nevi
•May also present in young children
•Characterized by large abnormally distributed junctional nests
•Pagetoid spread (can mimic superficial spreading melanoma)
•Atypical dermal component
•Junctional & dermal mitotic activity
•Impaired or absent maturation
•Involvement of the appendages

Diagnosis very much depends on clinicopathological correlation. It would be easy to make a misdiagnosis of dysplastic nevus or melanoma if the clinical information is unknown.
Melanoma arising in a congenital nevus
•Although the vast majority arise in giant forms, they may be encountered in smaller lesions & can be present at birth
•Develop in the dermal component
•Typical melanoma, nevoid melanoma, small cell melanoma, pleomorphic/anaplastic melanoma, melanoma with heterologous differentiation & malignant nerve sheath-like melanoma.
It is critical not to mistake a proliferative lesion for melanoma (see separate blog)
This melanoma arose in a small congenital nevus of the scalp. It metastasized widely. Varying features in different fields.

•

Leave a comment